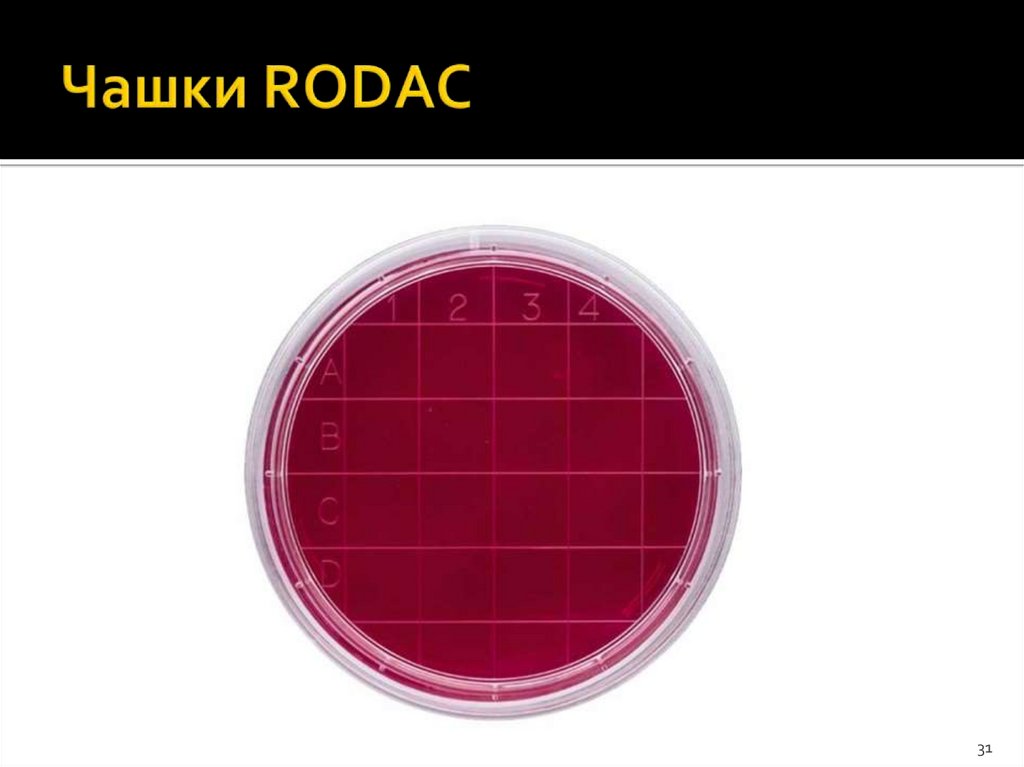
Чашки RODAC

Similar presentations:
Производственная гигиена. Использование воды в производстве косметической продукции. Мониторинг производственной среды
1. Производственная гигиена. Использование воды в производстве косметической продукции. Мониторинг производственной среды на
МИНИСТЕРСТВО ОБРАЗОВАНИЯ И НАУКИ РОССИЙСКОЙ ФЕДЕРАЦИИФедеральное государственное бюджетное образовательное учреждение высшего
образования
«Вятский государственный университет»
Институт биологии и биотехнологии
Кафедра микробиологии
Презентация к теме №12 по дисциплине «Микробиологический контроль
сырья и готовой продукции»
1
2. Меры от порчи
Для защиты продуктов от порчи илизагрязнения микроорганизмами принимаются
два типа мер:
меры по консервации;
меры по обеспечению гигиены.
2
3. Меры по консервации
Добавление консервантов гарантируетмикробиологическую стабильность продукта.
Правильно подобранная современная упаковка
продукта является дополнительной мерой
защиты: она уменьшает вероятность
попадания микроорганизмов в продукт из
окружающей среды во время использования.
Нельзя использовать избыток консервантов
для компенсации недостатков
производственной гигиены.
3
4. Обеспечение гигиены
Меры по обеспечению гигиеныпредотвращают контаминацию, пресекая
основные пути занесения микроорганизмов и
уничтожая их источники.
Они совершенно разные и направлены на все
возможные пути заражения.
Абсолютная стерильность не всегда
возможна при изготовлении косметики
Нельзя полностью избавиться от
консервантов, даже если производственная
гигиена безупречна.
4
5. Гигиена
- превентивная мера.Соблюдение гигиенических мероприятий является
затратным для руководства предприятий.
Индивидуальные части системы обеспечения гигиены
важны, но они обладают малой эффективностью.
Оптимальные результаты получаются только тогда,
когда меры по обеспечению гигиены принимаются в
рамках всей системы.
Если индивидуальные меры гигиены не
координированы, полученные результаты
обеспечивают качество продукции лишь по воле
случая.
5
6. Система гигиенических мероприятий
Гигиенические мероприятия необходимоадаптировать к специфике производственного
процесса.
Такой подход позволит получить эффективную и
экономически выгодную систему поддержания
гигиены.
Эта система должна учитывать спектр
производимых данной компанией продуктов и
её технические возможности.
Нужно своевременно адаптировать систему к
новым требованиям, возникающим в связи с
новыми разработками, новыми типами
производимых продуктов или новыми рабочим
ситуациями
6
7. Система гигиенических мероприятий
Разработанные меры по поддержанию гигиеныдолжны быть оформлены на предприятии как
инструкции.
Эти меры должны приниматься постоянно в
процессе работы и восприниматься как
неотъемлемая часть должностных инструкций.
Точность и эффективность гигиенических мер
необходимо постоянно контролировать и
проверять (микробиологические тесты,
химические анализы (концентрация
консервантов) и технические замеры
производственных систем (например,
температурный режим в процессе производства,
разность давлений в процессе фильтрации и т.д.).
7
8. Применение системы ХАССП
Основного различия между обстановкой в пищевом и вкосметическом секторе.
Термин «опасный» в контексте пищевой промышленности продукт, вызывающего значительный риск для здоровья. Этот
термин трудно перенести в контекст косметической
промышленности. Некоторые аспекты требуемой «оценки
рисков» также с трудом применяются по отношению к
косметическому производству.
В пищевом секторе наиболее высокий риск контаминации
возникает в процессе производства, а в косметическом секторе
самым рисковым является процесс разработки продукта.
В России в косметической отрасли более применимы правила
GMP
8
9. Дезинфекция
должна быть максимально эффективной приминимуме затраченных средств.
Во время составления инструкций о проведении работ по
дезинфекции нужно руководствоваться пятью основными
вопросами:
- чем дезинфицировать: выбор подходящих дез. средств;
- когда дезинфицировать: выбор этапа производственного
процесса, на котором нужно проводить дезинфекцию.
- как/как долго дезинфицировать: выбор необходимой
концентрации и подходящего времени действия средства,
выбор способа нанесения дез. средства.
- где/что дезинфицировать: выбор и обозначение критических
зон.
9
10. Вода в косметической промышленности
Вода - ключевое сырьё для косметическогосектора.
Производственная система, в которой
находится вода, должна быть спроектирована
таким образом, чтобы размножение бактерий в
ней подавлялось и предотвращалось.
С контаминацией нужно бороться в процессе
первичной очистки воды, то есть ещё перед
тем, как она попадает в нефасованный
продукт.
Воду обычно не стерилизуют, поэтому нужна
оценка уровня ее микробиологического
загрязнения.
10
11. Вода в косметической промышленности
Обычно для производства косметики используетсяпитьевая вода, удовлетворяющая всем
микробиологическим нормам, установленным для
этого типа воды. Но стандарт качества питьевой
воды не полностью совпадает со стандартом
качества технической (используемой) воды. Из-за
этого питьевая вода нуждается в
антибактериальной обработке.
Минимальное требование, предъявляемое к
технической воде, заключается в том, что
количество микроорганизмов должно быть менее
100 КОЕ на мл.
11
12. Вода в косметической промышленности
По стандартам микробиологическогомониторинга производственной среды
выделяются следующие уровни
содержания микроорганизмов:
*Предельно допустимый уровень < 100
КОЕ/мл
*Уровень действия 50-99 КОЕ
*Уровень тревоги 10-49 КОЕ/мл
*Предел толерантности < 10 КОЕ/мл
12
13. Основные методы обработки воды:
1. Фильтрация.Обычно проводится фильтрация крупнодисперсных (2050 мкм) и мелкодисперсных (5-10 мкм) частиц.
2. Дехлорирование воды
2.1. Дехлорирование воды с помощью активного
угольного фильтра.
2.2. Дехлорирование воды с помощью сульфита натрия.
3. Очистка воды из колодцев от железа и марганца.
4. Очистка воды с помощью УФ-излучения.
5. Химическая/физическая обработка поступающей воды.
6. Термообработка воды
7. Химическая дезинфекция.
Воду дезинфицируют хлором, озоном, альдегидами или
перекисями.
13
14. Мониторинг гигиены нужен
Удостоверение в выполнении требованийк чистоте помещений;
Отслеживание эффективности
выполнения мер по обеспечению
микробиологической безопасности;
Выявление слабых мест и пробелов в
санитарно-гигиенической системе
предприятия;
Предотвращение микробиологической
контаминации и прочее
14
15. Микробиологическому мониторингу должны подвергаться :
- воздух помещений;- технологическое оборудование;
- инструментарий;
- рабочие поверхности;
- руки оператора в перчатках;
- одежда персонала;
- контейнеры, в которых хранится продукт;
- вода;
- сжатый воздух, инертные газы.
- стены, пол и потолок помещения;
- двери;
- мебель и транспортные тележки;
- контейнеры для сбора отходов;
- инструменты и приборы для тестирования.
15
16. Точки отбора
1617. Точки отбора
- зоны наиболее высокой вероятностиконтаминации продукта;
- зоны наибольшего риска скопления
микроорганизмов при нормальном рабочем
процессе (накопление пыли на поверхностях с
электростатическими свойствами, более холодных
поверхностях; дверные ручки и т.д.);
- труднодоступные зоны для уборки и
дезинфекции;
- потенциальные источники контаминации;
- зоны возмущения воздушного потока рельефом
поверхности, смешение потоков.
17
18. Микробиологические методы мониторинга
Мониторинг промышленной гигиеныосуществляют с помощью следующих
микробиологических методов:
А. Культуральные методы
Метод агаровых контактных чашек
Исследование смыва
Метод мембранных фильтров, глубинный
посев или посев разливом на твердую среду
Б. Экспресс-методы Измерение
биолюминесценции Измерение импеданса
18
19. Методы тестирования воздушной среды
Для контроля микробной контаминациивоздуха применяют два метода:
пассивный (качественный)
активный (количественный) – с
применением специального оборудования
19
20. Пассивный метод
заключается в экспозиции открытойплотной питательной среды в течение определенного
периода времени.
Фактически данный метод является качественным и
позволяет лишь определить спектр присутствующих
микроорганизмов.
Время экспозиции составляет от 15 мин до нескольких
часов. Однако длительная экспозиция приводит к
высыханию поверхности питательной среды и к
ухудшению условий сохранения и культивирования
бактерий.
Этот метод широко распространен и его применение
целесообразно в сочетании с активным методом контроля
микробной контаминации воздуха.
Открытые чашки Петри располагают в нескольких точках.
20
21. Пассивный метод
2122. Методы отбора проб с поверхностей
Для контроля микробной контаминациирабочих поверхностей используются
следующие методы:
- смыв;
- контактная пластина.
Репрезентативной считается проба, снятая с
поверхности площадью от 24 до 30 см2.
22
23. Смывы
смывы с объектов окружающей средыпроводят до начала работы, либо во
время производственного процесса после
проведения надлежащей обработки
поверхности.
В случае необходимости выявления
источника обсеменения при
установленной микробной контаминации
отбор производят с необработанных
поверхностей.
23
24. Сывы
При отборе смывов с поверхности необходимоувлажненный стерильной пептонной водой, внесенной
в каждую пробирку в количестве не менее 2,0 мл.
Допускается смачивание тампона транспортной
средой, а также использование стерильных зондтампонов (свабов, тупферов и т.д.) промышленного
производства.
В идеале раствор, которым смачивают, уже должен
содержать смесь, инактивирующую консерванты: 3%
твина-80, 0,3% лецитина и 0,1% гистидина.
Далее микроорганизмы переносят с тампона на
твердую питательную среду (бактерии лучше растут на
казеиново-соевом пептонном агаре, а грибы - на среде
Сабуро).
24
25. Смывы
Если исследуемая поверхность сильно загрязнена,раствор, содержащий микроорганизмы, можно
дополнительно разбавить.
В конечном итоге общее микробное число
определяют, нанося аликвоты раствора на
поверхность или вглубь агара разливом на твердую
среду или методом глубинного посева,
соответственно.
Преимущество экстракции после смыва тампоном
состоит в том, что можно разбавить суспензию
микроорганизмов и поместить полученные
аликвоты на несколько чашек сразу.
25
26. Рекомендации по взятию смыва:
- смывы с площади меньше или равной 10 x 10см (100 см2) отбирают стерильным тампоном с
хлопком или синтетическим материалом;
- при отборе смывов с площади более 100 см2
следует использовать салфетку (5 * 5 см);
- смывы с мелких объектов (поверхность
которых менее 100 см2) берут со всей
поверхности; при необходимости - с
нескольких единиц одноименных предметов;
- смывы с перчаток берут только с наружной
стороны ладонной поверхности
26
27. Рекомендации по взятию смыва:
- при взятии смывов с рук протирают тампоном ладонныеповерхности обеих рук, проводя не менее 5 раз по каждой
ладони и пальцам, потом протирают межпальцевые
пространства, ногти и подногтевые пространства;
- при взятии смывов с мелких инструментов обтирается
вся поверхность предмета. При взятии смывов с мелких
предметов одним тампоном протирают три одноименных
объекта.
- смывы с санитарной одежды отбирают с помощью
тампонов с четырех участков, каждый из которых должен
быть не менее 25 см2, а именно нижняя часть каждого
рукава и две площадки с верхней и средней частей
передних пол одежды;
- если при взятии смывов с ровной рамки-трафареты,
ограничивающие площадь взятия смывов, то такие
рамки-трафареты должны быть стерильны.
27
28.
2829. Смывы
При взятии смывов составляется документ,включающий в себя информацию, необходимую
для однозначной идентификации объекта, места
взятия, основания и условий отбора, даты и
времени взятия проб, условия и сроки доставки и
иные дополнительные сведения.
Документ подписывают специалист, проводивший
отбор, представитель объекта, на котором
производилось взятие смывов, иные
заинтересованные лица.
Время доставки смывов в лабораторию не должно
превышать 6 часов с момента взятия, если иное не
валидировано аккредитованной обеспечивающее
достоверный результат.
29
30. Метод агаровых контактных чашек или пластин
Чашки RODAC (Replicate Organism DetectionAgar Contact plates - агаровые контактные
чашки для обнаружения размножения
организмов. Чашки покрыты агаром с
различными добавками.
Слайд-тесты Хигикульт (Schulke&Mayr)
агаром покрыты обе стороны носителя, так
что один слайд-тест можно использовать для
проверки двух поверхностей.
Система Biotest GK-A (Biotest) представляет
собой плёнку, покрытую слоем агара
(больший объем, более тонкое покрытие)
30
31. Чашки RODAC
3132.
3233. Метод агаровых контактных чашек
В том случае, когда контактная поверхностьсильно загрязнена, колонии довольно быстро
срастаются и покрывают всю поверхность чашки
равномерным слоем, поэтому подсчитать
количество колоний не удаётся.
Сплошной слой клеток может образоваться на
поверхности агара даже в том случае, если
поверхность контакта не была сильно загрязнена,
но некоторые микроорганизмы склонны к
быстрому росту и формируют очень крупные
колонии. В этом случае рекомендуется сократить
время инкубации и проводить промежуточные
подсчеты колоний в процессе инкубации.
33
34. Метод агаровых контактных чашек
Метод не рассчитан на адекватный анализобразцов, взятых с влажных поверхностей.
При контакте с влажной поверхностью на
поверхности агара образуется тонкая плёнка
жидкости, в которой бактерии могут двигаться.
Из-за этого образуются сателлитные колонии, и
чашки зарастают ровным слоем. Кроме того,
твердые питательные среды, контактирующие с
влажной поверхностью, хуже адсорбируют
бактерии.
перед осуществлением контакта с исследуемой
поверхностью поверхность твердой питательной
среды необходимо подсушить
34
35. Метод агаровых контактных чашек
Все разновидности метода контактныхчашек имеют одну общую особенность:
при анализе охватывается только
небольшая часть поверхности.
Использование этого метода, по сути
своей, является анализом случайной
выборки и не позволяет получить
количественные данные об уровне
контаминации на всей исследуемой
поверхности.
35

biology
biology








